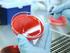
Antibiotika. Definition. Bedeutung. Substanzen, die den Infektionserreger, aber nicht den Makroorganismus schädigen. (Paul Ehrlich: Magische Kugel )

:43
|
|
|
- Berthold Hertz
- vor 8 Jahren
- Abrufe
Transkript
1 :43
2 HINWEIS Wertes Auditorium, die medizinisch-wissenschaftlichen Informationen dieser Präsentation spiegeln ausschließlich meine eigene Meinung und/oder Erfahrung wider. Der vollständige Einklang der Inhalte mit den jeweiligen Fachinformationen (Austria Codex) kann daher von Seiten des Sponsors (Zulassungsinhabers) dieser Fortbildungsveranstaltung nicht gewährleistet werden.
3 Resistenzprobleme ESBL MRSA Der Spiegel 2011
4 Evolution der Gram-neg Resistenz Livermore, CID 2002 Hawkey, AAC 2008 Hawkey, JAC 2009 Bush, AAC 2010 Olivares, Front Microbioal 2013 AURES 2014 Rossolini, Integrated symposium IS08, 25th ECCMID 2015 m Forstner, Anästhesiol Intensivmed Notfallmed Schmerzther 2016
5 Betalaktame & Betalaktamasen Theuretzbacher, Pharm unserer Zeit 2006
6 Betalaktamasen Bush, Rev Inf Dis 1987 Bush, Antimicrob Agents Chemother 1959 Bradford, Clin Microbiol Rev 2001 Bush, Curr Opin Investig Drugs 2002 Jacoby, Clin Microbiol Rev Stuart, Int J Antimicrob Agents. 2010
7 Betalaktamasen bei Enterobakterien Ruppe, Ann Intensive Care 2015
8 ESBL-Häufigkeit bei Enterobakterien EHER HÄUFIG Klebsiella spp. Escherichia coli Proteus mirabilis EHER SELTEN Enterobacter spp. Pseudomonas aeruginosa Citrobacter freundii Morganella morganii Serratia marcescens
9 :48 MRGN-THERAPIE IM SPITAL Therapieoptionen Enterobakterien 4 MRGN Colistin (Fosfomycin) Tigecyclin AKH Wien 2016
10 Colistin Pseudomonas aeruginosa (MDR) Acinetobacter baumanii (MDR) Klebsiella pneumoniae (KPC) Gurjar, J Intensive Care 2014
11 Colistin LD: 12 Mio IU KG-unabhängig - killing-rate 12 Mio: 75% - killing-rate 09 Mio: 55% - killing-rate 06 Mio: 45% Infusionsdauer bis zu 2 Std - Abtötungsrate nicht niedriger zu 15 oder 30 min Infusionsdauer ED: 4.5 Mio IU 2 x tgl. - Aufteilung auf 3 x tgl möglich Mohamed, J Antimicrob Chemother 2014
12 Colistin Daptomycin zur Therapie von Acinetobacter baumanii Maimberg, P1817 ECCMID 2012 Cubicin
13 Colistin
14 300 mg MRGN-THERAPIE IM SPITAL Tigecyclin
15 Tigecyclin Dosierung lt Fachinformation Tg1 LD 1 x 100 mg, ab Tg2 ED 2 x 50 mg Dosis (mg) TIG-Gabe mit glz. Nahrungsaufnahme reduziert Übelkeit. Infusionsdauer über 4 Stunden erhöht Übelkeitsrisiko. Wyeth, Data on file
16 Der Betalaktamring Holzgrabe, Pharmazie aus unserer Zeit 2006
17 Carbapeneme Streptokokken Entero- DOSIERUNG Nonfermentor Anaerobier MSSA bakterien Imipenem Meropenem Limited + 3 x activity g? Ertapenem + +? Doripenem ?
18 Carbapeneme Meropenem Beck, Anästhesist 2014
19 Carbapeneme Carbapenem Breakpoint S R > Doripenem 1 4 Ertapenem - - Imipenem 4 8 Meropenem 2 8 MHK (mg/l) 54% Imipenem 4 x 500 mg Doripenem 3 x 500 mg Doripenem & Imipenem
20 Meropenemdosierung bei MDR-PSAE Taccone, Antimicrob Agents Chemother 2012
21 Einfluß des Resistenzmechanismus Efflux ± Porine Mutation der Zielstruktur Enzym mediiert S sensibel I intermediär R resistent
22 20:03 MRGN-THERAPIE IM SPITAL OPTION I Optionen Antibiotic Stewardship OPTION II Alternativen nur bei Penem-Resistenz OPTION III Alternativen vorbeugend um Penem-Resistenz zu vermeiden
23 Betalaktamaseinhibitore Hemmung einiger Klasse A Betalaktamasen Hemmung von Klasse A & C Betalaktamasen: ESBL, AmpC, KPC Variable Hemmung von Klasse D Betalaktamasen KEINE HEMMUNG VON KLASSE B BETALAKTAMSEN
24 Avibactam Differenzierung zu anderen BLI - keine b-laktam-struktur - Wiederherstellung der Aktivität von Ceftazidim und anderen Betalaktam-Antibiotika gegen Kl A, Kl C und einige Kl D Betalaktamaseinhibitoren - keine Induktion von Betalaktamasen - 50% niedrigere Wirkkonzentration notwendig Lahiri, Antimicrob Agents Chemother 2013
25 Betalaktamaseinhibitor Turnover Zahl der Moleküle (t n ), die bis zu einer irreversiblen Hemmung der Betalaktamase verbraucht werden. Avibactam 1 5 Moleküle notwendig, um 1 BL-Molekül zu hemmen Stachyra, Antimicrob Agents Chemother 2009 Drawz, Clin Microbiol Rev 2010 Toussaint, Ann Pharmacother 2014
26 Aktivität neuer BL-BLI-Kombinationen Shlaes, Ann N Y Acad Sci 2013
27 Pharmakodynamik von BL/BLI BLI muss Betalaktamase während BL-Aktivität inaktivieren Berkhout, ICAAC 2013; Poster A-1023 Coleman, Antimicrob Agents Chemother 2014
28 BLI-Kombinationen Clavulansäure - Amoxicillin (Augmentin ) ambulant erw. Pneumonie 3 x 4.4 g i.v. - Ticarcillin Pseudomonasinfektion 3 x 3.1 g i.v. Sulbactam - Ampicillin (Unasysn ) Harnwegsinfektion 3 x 6.0 g i.v. Tazobactam - Piperacillin (Tazonam ) Pseudomonasinfektion 3 x 4.5 g i.v. - Ceftolozan/Tazobactam (Zerbaxa ) Pseudomonasinfektion 3 x 3.0 g i.v. Avibactam - Ceftazidim/Avibactam (Zavicefta ) Pseudomonasinfektion 3 x 2.5 g i.v.
29 Anzahl der E. coli Stämme (n) CEF Cefepim CEF+CLAV Cefepim + Clavulansäure MRGN-THERAPIE IM SPITAL Clavulansäure = n = 308 Livermore, J Antimicrob Chemother 2008
30 Amoxicillin/Clavulansäure MHK THERAPIE ERFOLG VERSAGEN 1 mg/l 81% 19% 2 mg/l 67% 33% 4 mg/l 27% 73% 8 mg/l 11% 89% Andes, Clin Microbiol Infect 2005 Mikrobiologie AKH & MU Wien
31 BLI-Aktivität normale & reduzierte GFR Wright, J Antimicrob Chemother 1983 Horber, Antimicrob Agents Chemother 1986
32 Aminopenicillin & BLI Amoxicillin/Clavulansäure Erfahrung mit hohen Dosen BLI stabiler PRO Kindersaft Hepatoxizität unterschiedliche PK BLI-Verhältnis sehr variabel Ampicillin/Sulbactam Ampi&Sulbac-PK ähnlich keine BL-Induktion BLI gut verträglich höhere BLI-Dosis (4 g) mögl Infusion länger (8 h) stabil orale Dosierung? CONTRA Infusion nur 30 min stabil Dosis 3 x g i.v. 2 4 x 1000 mg p.o. = max mg Amoxi Dosis 3 x g i.v. 2 3 x mg p.o. = max mg Ampi
33 :08 MRGN-THERAPIE IM SPITAL Tazobactam reduziert renale Sekretion von Piperacillin > höhere Piperacillin-Blutspiegel schützt Piperacillin vor Hydrolyse durch Betalaktamasen 10-fach aktiver als Clavulansäure gegen TEM Inoculum-Effekt Wildtyp AmpC induzierende Enterobakterien - Mittel der Wahl (bzw. Ticarcillin) - Vermeidung von Ceph III - Vermeidung von Clavulansäure (induziert AmpC bei PAE) Komuro, JAC 1994 Bonfiglio, Duagn Microbiol Infect Dis 1994 Bonomo, FEMS Microbiol Lett 1997 Lister, AAC 1999 Thomson, AAC 2001 Shlaes, Ann N Y Acad Sci 2013 Harris, Lancet Infect Dis 2015 Ruppé, Ann Intensive Care 2015
34 AmpC Carbapenem vs PipiTaz Harris, J Antimicrob Chemother 2016
35 pro&con BLBLI bei ESBL Harris, Lancet Infect Dis 2015
36 Betalaktamasen Breitspektrum Betalaktamase TEM-1, SHV-1 SERIN Klasse A Extended-Spektrum Betalaktamase (ESBL) CTX-M-14/15 TEM-2, SHV-2 Betalaktamase Carbapenemase KPC BETA LAKTAMASEN Klasse C Extendes-Spektrum Cephalosporinase AmpC Carbapenemase OXA-48 Klasse D Oxacillinase OXA-11 METALLO Betalaktamase Klasse B Carbapenemase IMP, NDM, VIM GRUPPE KLASSE SUBSTRAT ENZYM
37 Temocillin Breitspektrum Betalaktamase TEM-1, SHV-1 SERIN Klasse A Extended-Spektrum Betalaktamase (ESBL) CTX-M-14/15 TEM-2, SHV-2 Betalaktamase Carbapenemase KPC BETA LAKTAMASEN Klasse C Extendes-Spektrum Cephalosporinase AmpC Carbapenemase OXA-48 Klasse D Oxacillinase OXA-11 METALLO Betalaktamase Klasse B Carbapenemase IMP, NDM, VIM GRUPPE KLASSE SUBSTRAT ENZYM
38 Temocillin Therapiealternative Temocillin AmpC- und ESBL stabil KPC aktiv in vitro KEINE AKTIVITÄT bei OXA-48 Metallobetalaktamasen P. aeruginosa Balakrishnan, J Antimicrob Chemother 2011 Forstner, Krankenhaushygiene up2date 2014 l Laterre, J Antimicrob Chemother 2014
39 Ceph-Struktur-Aktivitäts-Beziehungen Chellat, Angew Chemie 2016
40 Ceftazidim/Avibactam Breitspektrum Betalaktamase TEM-1, SHV-1 SERIN Klasse A Extended-Spektrum Betalaktamase (ESBL) CTX-M-14/15 TEM-2, SHV-2 Betalaktamase Carbapenemase KPC BETA LAKTAMASEN Klasse C Extendes-Spektrum Cephalosporinase AmpC Carbapenemase OXA-48 Klasse D Oxacillinase OXA-11 METALLO Betalaktamase Klasse B Carbapenemase IMP, NDM, VIM GRUPPE KLASSE SUBSTRAT ENZYM
41 Ceftazidim/Avibactam MHK's von 42 KPC-positiven K. pneumoniae US-Stämmen Endimiani, Antimicrob Agents Chemother 2009
42 Ceftazidim/Avibactam & Enterobakterien Livermore, Antimicrob Agents Chemother 2011 Livermore, ECCMID 2015
43 Ceftolozan/Tazobactam Breitspektrum Betalaktamase TEM-1, SHV-1 SERIN Klasse A Extended-Spektrum Betalaktamase (ESBL) CTX-M-14/15 TEM-2, SHV-2 Betalaktamase Carbapenemase KPC BETA LAKTAMASEN Klasse C Extendes-Spektrum Cephalosporinase AmpC Carbapenemase OXA-48 Klasse D Oxacillinase OXA-11 METALLO Betalaktamase Klasse B Carbapenemase IMP, NDM, VIM GRUPPE KLASSE SUBSTRAT ENZYM
44 Ceftolozan/Tazobactam Zhanel, Drugs 2014
45 Ceftolozan/Tazobactam Riera, JAC 2001 Livermore, CID 2002 Zhanle, Drugs 2007 Davies, JAC 2011 Crandon, AAC 2012 Cubist, Data on file 2014 Bassetti, Future Microbiol 2015
46 Ceftolozan/Tazobactam Bassetti, Future Microbiol 2015
47 Ceftolozan/Tazobactam & P. aeruginosa Sader, Antimicrob Agents Chemother 2011 Livermore, ECCMID 2015
48 Ceftolozan/Tazobactam Farrell, ECCMID 2015
49 Pseudomonas aeruginosa Kühnen, Dtsch Beratungszentrum Hygiene Freiburg 2016
50 Imipenem/Relebactam Breitspektrum Betalaktamase TEM-1, SHV-1 SERIN Klasse A Extended-Spektrum Betalaktamase (ESBL) CTX-M-14/15 TEM-2, SHV-2 Betalaktamase Carbapenemase KPC BETA LAKTAMASEN Klasse C Extendes-Spektrum Cephalosporinase AmpC Carbapenemase OXA-48 Klasse D Oxacillinase OXA-11 METALLO Betalaktamase Klasse B Carbapenemase IMP, NDM, VIM GRUPPE KLASSE SUBSTRAT ENZYM
51 Relebactam Hecker, J Med Chem 2015
52 Aztreonam/Avibactam Breitspektrum Betalaktamase TEM-1, SHV-1 SERIN Klasse A Extended-Spektrum Betalaktamase (ESBL) CTX-M-14/15 TEM-2, SHV-2 Betalaktamase Carbapenemase KPC BETA LAKTAMASEN Klasse C Extendes-Spektrum Cephalosporinase AmpC Carbapenemase OXA-48 Klasse D Oxacillinase OXA-11 METALLO Betalaktamase Klasse B Carbapenemase IMP, NDM, VIM GRUPPE KLASSE SUBSTRAT ENZYM
53 Aztreonam/Avibactam & MBL-Enterobak Livermore, Antimicrob Agents Chemother 2011 Livermore, ECCMID 2015
54 Neue BL/BLI-Kombinationen Kern, Internist 2015
55 Quanta costa? BILLIG ist TEUER TEUER ist BILLIG Prabhu, ISPOR 18 th Annual European Congress 2015
56 Zusammenfassung Mikrobiologie wichtiger, denn je Carbapeneme nur bei entsprechender Indikation - De-Eskalation, wo möglich Alternativen (Amoxi/Clav, Pip/Taz) einsetzen Cephalosporine nach Möglichkeit vermeiden BL/BLI-Kombinationen anstelle von Carbapenemen - Kostenfrage!! KH-Hygiene strikt beachten Isolierung von Risikopatienten (Anamnese)
57 COOMING soon ERHÄLTLICH im itunes Store
Gramnegative multiresistente Erreger eine unterschätzte Gefahr
 Gramnegative multiresistente Erreger eine unterschätzte Gefahr Dr. Martin Kaase NRZ für gramnegative Krankenhauserreger Ruhr-Universität Bochum [email protected] E. coli Wildtyp Ampicillin Piperacillin
Gramnegative multiresistente Erreger eine unterschätzte Gefahr Dr. Martin Kaase NRZ für gramnegative Krankenhauserreger Ruhr-Universität Bochum [email protected] E. coli Wildtyp Ampicillin Piperacillin
Klassifizierung multiresistenter Keime. Dr. Ingrid Heller Sektion für Hygiene und Medizinische Mikrobiologie Hygieneteam LKI
 Klassifizierung multiresistenter Keime Dr. Ingrid Heller Sektion für Hygiene und Medizinische Mikrobiologie Hygieneteam LKI Definition Multiresistenz Mycobacteriumtuberculosis: MDR: Resistenz gegen INH
Klassifizierung multiresistenter Keime Dr. Ingrid Heller Sektion für Hygiene und Medizinische Mikrobiologie Hygieneteam LKI Definition Multiresistenz Mycobacteriumtuberculosis: MDR: Resistenz gegen INH
Bedeutung, Behandlung, Prophylaxe
 ESBL und andere mulitresistente gramnegative Keime Bedeutung, Behandlung, Prophylaxe Dr. Martin Kaase NRZ für gramnegative Krankenhauserreger Ruhr-Universität Bochum [email protected] E. coli Wildtyp
ESBL und andere mulitresistente gramnegative Keime Bedeutung, Behandlung, Prophylaxe Dr. Martin Kaase NRZ für gramnegative Krankenhauserreger Ruhr-Universität Bochum [email protected] E. coli Wildtyp
N O. Betalaktam-Ring. Penizilline. Carbapeneme. Cephalosporine. Gram negative Resistenzkeime. Mikrobiologie für Nicht-Mikrobiologen
 Übersicht Gram negative esistenzkeime Mikrobiologie für icht-mikrobiologen ygienesymposium 2013 Morschach Betalaktam Chinolone Cotrimoxazol Aminoglykoside Tetrazykline Gerhard Eich, Stadtspital Triemli
Übersicht Gram negative esistenzkeime Mikrobiologie für icht-mikrobiologen ygienesymposium 2013 Morschach Betalaktam Chinolone Cotrimoxazol Aminoglykoside Tetrazykline Gerhard Eich, Stadtspital Triemli
Enterobacteriaceae und konventionelle Methoden zu ihrer Detektion
 Epidemiologie von Carbapenemasebildenden Enterobacteriaceae und konventionelle Methoden zu ihrer Detektion Dr. Martin Kaase NRZ für gramnegative Krankenhauserreger Ruhr-Universität Bochum [email protected]
Epidemiologie von Carbapenemasebildenden Enterobacteriaceae und konventionelle Methoden zu ihrer Detektion Dr. Martin Kaase NRZ für gramnegative Krankenhauserreger Ruhr-Universität Bochum [email protected]
Infektionen durch CPE & Co therapieren. Robert Krause Universitätsklinik f. Innere Medizin Medizinische Universität Graz
 Infektionen durch CPE & Co therapieren Robert Krause Universitätsklinik f. Innere Medizin Medizinische Universität Graz CPE und Co CPE Carbapenemase produzierende Enterobakterien Co Pseudomonas aeruginosa
Infektionen durch CPE & Co therapieren Robert Krause Universitätsklinik f. Innere Medizin Medizinische Universität Graz CPE und Co CPE Carbapenemase produzierende Enterobakterien Co Pseudomonas aeruginosa
FLORIAN THALHAMMER UNIVERSITÄTSKLINIK FÜR INNERE MEDIZIN I K l i n i s c h e A b t e i l u n g f ü r I n f e k t i o n e n & T r o p e n m e d i z i
 FLORIAN THALHAMMER UNIVERSITÄTSKLINIK FÜR INNERE MEDIZIN I K l i n i s c h e A b t e i l u n g f ü r I n f e k t i o n e n & T r o p e n m e d i z i n f l o r i a n. t h a l h a m m e r @ m e d u n i w
FLORIAN THALHAMMER UNIVERSITÄTSKLINIK FÜR INNERE MEDIZIN I K l i n i s c h e A b t e i l u n g f ü r I n f e k t i o n e n & T r o p e n m e d i z i n f l o r i a n. t h a l h a m m e r @ m e d u n i w
Neue Wege zur Reduktion der Antibiotikaverordnung bei Atemwegsinfektionen.
 Neue Wege zur Reduktion der Antibiotikaverordnung bei Atemwegsinfektionen. Epidemiologie der antimikrobiellen Resistenzen in Deutschland und Europa Miriam Wiese-Posselt Institut für Hygiene und Umweltmedizin
Neue Wege zur Reduktion der Antibiotikaverordnung bei Atemwegsinfektionen. Epidemiologie der antimikrobiellen Resistenzen in Deutschland und Europa Miriam Wiese-Posselt Institut für Hygiene und Umweltmedizin
Multiresistente Erreger. Welche sollen es denn diesmal sein? Stäbchen? Kokken? Spiralen?
 Hygiene in der Arztpraxis 3MRGN/4MRGN was ist das nun wieder?? 17.04.2013 Multiresistente Erreger Welche sollen es denn diesmal sein? Stäbchen? Kokken? Spiralen? Multiresistente Erreger Welche sollen
Hygiene in der Arztpraxis 3MRGN/4MRGN was ist das nun wieder?? 17.04.2013 Multiresistente Erreger Welche sollen es denn diesmal sein? Stäbchen? Kokken? Spiralen? Multiresistente Erreger Welche sollen
Mathias W. Pletz Zentrum für Infektionsmedizin und Krankenhaushygiene
 Multiresistente Erreger Mathias W. Pletz Zentrum für Infektionsmedizin und Krankenhaushygiene Inhalte 1. Wo liegt das Problem? 2. MRSA 3. 3 und 4 MRGN Infektionsmedizin im 15. Jahrhundert im 21. Jahrhundert?
Multiresistente Erreger Mathias W. Pletz Zentrum für Infektionsmedizin und Krankenhaushygiene Inhalte 1. Wo liegt das Problem? 2. MRSA 3. 3 und 4 MRGN Infektionsmedizin im 15. Jahrhundert im 21. Jahrhundert?
Krankenhaushygiene und Infektionsschutz: Gefahren erkennen: Neue Erreger auf dem Vormarsch
 Krankenhaushygiene und Infektionsschutz: Gefahren erkennen: Neue Erreger auf dem Vormarsch Petra Gastmeier Institut für Hygiene und Umweltmedizin, Charité Universitätsmedizin Berlin Die wichtigsten Erreger
Krankenhaushygiene und Infektionsschutz: Gefahren erkennen: Neue Erreger auf dem Vormarsch Petra Gastmeier Institut für Hygiene und Umweltmedizin, Charité Universitätsmedizin Berlin Die wichtigsten Erreger
ESBL heißt jetzt MRGN Neues über multiresistente gramnegative Erreger. Prof. Dr. C. Wendt
 ESBL heißt jetzt MRGN Neues über multiresistente gramnegative Erreger Prof. Dr. C. Wendt Weitere Co-Resistenzen E. coli ESBL+ / Chin-S E. coli ESBL+ / Chin-R Klebsiella spp. ESBL+ / Chin-S Klebsiella spp.
ESBL heißt jetzt MRGN Neues über multiresistente gramnegative Erreger Prof. Dr. C. Wendt Weitere Co-Resistenzen E. coli ESBL+ / Chin-S E. coli ESBL+ / Chin-R Klebsiella spp. ESBL+ / Chin-S Klebsiella spp.
Dosierung parenteraler ß-Laktame: Welche klinischen Vorteile bieten höhere Dosen und die kontinuierliche Infusion?
 Dosierung parenteraler ß-Laktame: Welche klinischen Vorteile bieten höhere Dosen und die kontinuierliche Infusion? Katja de With Medizinische Universitätsklinik Freiburg Entwicklung antibiotikaresistenter
Dosierung parenteraler ß-Laktame: Welche klinischen Vorteile bieten höhere Dosen und die kontinuierliche Infusion? Katja de With Medizinische Universitätsklinik Freiburg Entwicklung antibiotikaresistenter
Überblick über die Resistenzlage (insbesondere gramnegative Erreger)
 Überblick über die Resistenzlage (insbesondere gramnegative Erreger) Dr. med. Martin Kaase NRZ für gramnegative Krankenhauserreger Ruhr-Universität Bochum [email protected] MRSA MRSA (%) 40 35 30 25
Überblick über die Resistenzlage (insbesondere gramnegative Erreger) Dr. med. Martin Kaase NRZ für gramnegative Krankenhauserreger Ruhr-Universität Bochum [email protected] MRSA MRSA (%) 40 35 30 25
Kommentar zum Ringversuch B9 Mikrobiologie 2012-2
 Verein für medizinische Qualitätskontrolle Association pour le contrôle de Qualité medical Associazione per il controllo di qualità medico Kommentar zum Ringversuch B9 Mikrobiologie 2012-2 Probe A: Peritonealexsudat
Verein für medizinische Qualitätskontrolle Association pour le contrôle de Qualité medical Associazione per il controllo di qualità medico Kommentar zum Ringversuch B9 Mikrobiologie 2012-2 Probe A: Peritonealexsudat
Antibiotikaresistenz bei gramnegativen Bakterien
 Antibiotikaresistenz bei gramnegativen Bakterien - Fokus Carbapenemresistenz - Fachtagung multiresistente Erreger September 2012 Tilo Hackel LUA Dresden Antibiotikaresistenz ist die Folge von Antibiotikagebrauch.
Antibiotikaresistenz bei gramnegativen Bakterien - Fokus Carbapenemresistenz - Fachtagung multiresistente Erreger September 2012 Tilo Hackel LUA Dresden Antibiotikaresistenz ist die Folge von Antibiotikagebrauch.
Hygiene in der Arztpraxis
 Hygiene in der Arztpraxis 3MRGN/4MRGN Gefahr durch multiresistente Erreger? 22.04.2015 Multiresistente Erreger Welche sollen es denn diesmal sein? MRGN = Multiresistente Gramnegative Stäbchen Stäbchen?
Hygiene in der Arztpraxis 3MRGN/4MRGN Gefahr durch multiresistente Erreger? 22.04.2015 Multiresistente Erreger Welche sollen es denn diesmal sein? MRGN = Multiresistente Gramnegative Stäbchen Stäbchen?
ESBL, AmpC & Co. Beta-Lactamasen in Enterobacteriaceae
 Antibiotikaresistenz Gram-negativer nosokomialer Infektionserreger ESBL, AmpC & Co. Beta-Lactamasen in Enterobacteriaceae Yvonne Pfeifer Bad Honnef Symposium 2008 Enterobakterien (Enterobacteriaceae) als
Antibiotikaresistenz Gram-negativer nosokomialer Infektionserreger ESBL, AmpC & Co. Beta-Lactamasen in Enterobacteriaceae Yvonne Pfeifer Bad Honnef Symposium 2008 Enterobakterien (Enterobacteriaceae) als
Wie häufig sind ESBL- und Carbapenemaseproduzierende
 Wie häufig sind ESBL- und Carbapenemaseproduzierende E. coli in der Schweiz? PD Dr. med. Andreas Kronenberg Berner Infektiologie Symposium 20.11.2014 Institut für Infektionskrankheiten, Universität Bern
Wie häufig sind ESBL- und Carbapenemaseproduzierende E. coli in der Schweiz? PD Dr. med. Andreas Kronenberg Berner Infektiologie Symposium 20.11.2014 Institut für Infektionskrankheiten, Universität Bern
Hygienemaßnahmen bei Infektionen oder Besiedlung mit multiresistenten gramnegativen Stäbchen
 Hygienemaßnahmen bei Infektionen oder Besiedlung mit Empfehlung der Kommission für Krankenhaushygiene und Infektionsprävention (KRINKO) beim RKI Bundesgesundheitsblatt 2012, 55:1311-1354 20.02.2013 Dr.
Hygienemaßnahmen bei Infektionen oder Besiedlung mit Empfehlung der Kommission für Krankenhaushygiene und Infektionsprävention (KRINKO) beim RKI Bundesgesundheitsblatt 2012, 55:1311-1354 20.02.2013 Dr.
Antibiotikaresistenz und Therapieoptionen bei Harnwegsinfektionen
 Klinik und Poliklinik für Urologie, Kinderurologie und Andrologie JUSTUS- LIEBIG UNIVERSITÄT GIESSEN Antibiotikaresistenz und Therapieoptionen bei Harnwegsinfektionen Florian M.E. Wagenlehner Klinik und
Klinik und Poliklinik für Urologie, Kinderurologie und Andrologie JUSTUS- LIEBIG UNIVERSITÄT GIESSEN Antibiotikaresistenz und Therapieoptionen bei Harnwegsinfektionen Florian M.E. Wagenlehner Klinik und
Phänotypische & genotypische Detektion von Beta-Laktamasen
 Bad Honnef-Symposium 2013 Update Antibiotika-Resistenzen: Erkennen, Bewerten, Handeln, 25. - 26. März, Königswinter Phänotypische & genotypische Detektion von Beta-Laktamasen M 1 2 3 4 5 MP Dr. rer. nat.
Bad Honnef-Symposium 2013 Update Antibiotika-Resistenzen: Erkennen, Bewerten, Handeln, 25. - 26. März, Königswinter Phänotypische & genotypische Detektion von Beta-Laktamasen M 1 2 3 4 5 MP Dr. rer. nat.
MVZ Dr. Eberhard & Partner Dortmund - 1
 Überblick MRSA-Netzwerktreffen Kreis Multiresistente Erreger und Antibiotika Dr. med. Arthur Pranada Facharzt für Mikrobiologie, Virologie und Infektionsepidemiologie Antibiotic Stewardship (ABS-)Experte
Überblick MRSA-Netzwerktreffen Kreis Multiresistente Erreger und Antibiotika Dr. med. Arthur Pranada Facharzt für Mikrobiologie, Virologie und Infektionsepidemiologie Antibiotic Stewardship (ABS-)Experte
Multiresistenz sind wir noch zu retten?
 Multiresistenz sind wir noch zu retten? Dr. med. Béatrice Grabein Max von Pettenkofer-Institut für Hygiene und Medizinische Mikrobiologie Außenstelle Großhadern Béatrice Grabein Aktuelle Situation Resistenz-Entwicklung
Multiresistenz sind wir noch zu retten? Dr. med. Béatrice Grabein Max von Pettenkofer-Institut für Hygiene und Medizinische Mikrobiologie Außenstelle Großhadern Béatrice Grabein Aktuelle Situation Resistenz-Entwicklung
hmm-newsletter 1 (vom ) RESISTENZ GEGEN CARBAPENEME: CARBAPENEM-RESISTENTE GRAMNEGATIVE BAKTERIEN
 1. homepage: www2.i-med.ac.at/hygiene/ hmm-newsletter 1 (vom 1.11.2010) RESISTENZ GEGEN CARBAPENEME: CARBAPENEM-RESISTENTE GRAMNEGATIVE BAKTERIEN Monica V. Mango, Sektion HMM Tel.: 0512/9003-70764; [email protected]
1. homepage: www2.i-med.ac.at/hygiene/ hmm-newsletter 1 (vom 1.11.2010) RESISTENZ GEGEN CARBAPENEME: CARBAPENEM-RESISTENTE GRAMNEGATIVE BAKTERIEN Monica V. Mango, Sektion HMM Tel.: 0512/9003-70764; [email protected]
Empirische antibiotische Therapie bei schwerer Sepsis
 MEDIZINISCHE KLINIK TÜBINGEN Empirische antibiotische Therapie bei schwerer Sepsis Infektionsmedizin 2011 Reimer Riessen Internistische Intensivstation Bedeutung einer raschen Antibiotikatherapie Jede
MEDIZINISCHE KLINIK TÜBINGEN Empirische antibiotische Therapie bei schwerer Sepsis Infektionsmedizin 2011 Reimer Riessen Internistische Intensivstation Bedeutung einer raschen Antibiotikatherapie Jede
Antibiotikaresistenz Wie ernst ist die Lage?
 Antibiotikaresistenz Wie ernst ist die Lage? Dr med Olivier Dubuis, Viollier AG Antibiotikum Einführung Resistenzentwicklung Viollier AG 4123 Allschwil 09.08.2016 / 1 Staphylococcus aureus Trägerrate 20-40%
Antibiotikaresistenz Wie ernst ist die Lage? Dr med Olivier Dubuis, Viollier AG Antibiotikum Einführung Resistenzentwicklung Viollier AG 4123 Allschwil 09.08.2016 / 1 Staphylococcus aureus Trägerrate 20-40%
Multiresistente gramnegative Erreger - mikrobiologische und hygienische Aspekte. Dr. Uwe Lang Facharzt für Mikrobiologie Facharzt für Hygiene
 Multiresistente gramnegative Erreger - mikrobiologische und hygienische Aspekte Dr. Uwe Lang Facharzt für Mikrobiologie Facharzt für Hygiene Antibiotikatherapie und Sterblichkeit Ibrahim Chest 2000; Alvarez
Multiresistente gramnegative Erreger - mikrobiologische und hygienische Aspekte Dr. Uwe Lang Facharzt für Mikrobiologie Facharzt für Hygiene Antibiotikatherapie und Sterblichkeit Ibrahim Chest 2000; Alvarez
Ulkus als Quelle resistenter Erreger. O. Janata DSP
 Ulkus als Quelle resistenter Erreger O. Janata DSP Prämissen Jedes Ulkus ist baktreriell besiedelt Keine Antibiotika für Ulzera Keine Antibiotika für Abstriche Abstriche für die Krankenhaushygiene!
Ulkus als Quelle resistenter Erreger O. Janata DSP Prämissen Jedes Ulkus ist baktreriell besiedelt Keine Antibiotika für Ulzera Keine Antibiotika für Abstriche Abstriche für die Krankenhaushygiene!
Aktuelles zum Thema Antibiotika
 Erreger der ESCAPE-Gruppe Die Ausbreitung von Infektionen durch multiresistente Erreger schreitet rasant voran. Aktuelles zum Thema Antibiotika Dr. Kathrin Marx E = Enterokokken, Vancomycin-resistent (VRE)
Erreger der ESCAPE-Gruppe Die Ausbreitung von Infektionen durch multiresistente Erreger schreitet rasant voran. Aktuelles zum Thema Antibiotika Dr. Kathrin Marx E = Enterokokken, Vancomycin-resistent (VRE)
Multiresistente Gram-negative Bakterien (MRGN) Problemkeime des 21. Jahrhunderts
 Multiresistente Gram-negative Bakterien (MRGN) Problemkeime des 21. Jahrhunderts Prävention der Ausbreitung Präzise und rasche Diagnostik Konsequente Infektionskontrolle Rationaler Antibiotika- Einsatz
Multiresistente Gram-negative Bakterien (MRGN) Problemkeime des 21. Jahrhunderts Prävention der Ausbreitung Präzise und rasche Diagnostik Konsequente Infektionskontrolle Rationaler Antibiotika- Einsatz
:13
 www.fu-berlin.de 01.04.2015 15:13 HINWEIS Wertes Auditorium, die medizinisch-wissenschaftlichen Informationen dieser Präsentation spiegeln ausschließlich meine eigene Meinung und/oder Erfahrung wider.
www.fu-berlin.de 01.04.2015 15:13 HINWEIS Wertes Auditorium, die medizinisch-wissenschaftlichen Informationen dieser Präsentation spiegeln ausschließlich meine eigene Meinung und/oder Erfahrung wider.
Multiresistente Bakterien. Was bedeuten sie für uns?
 Multiresistente Bakterien Was bedeuten sie für uns? Hygiene im Langzeitpflegebereich, PZ Gerenholz, 19.5.2016 Gerhard Eich Infektiologie/Spitalhygiene Stadtspitäler Triemli & Waid Patient, geb. 1949 Persönliche
Multiresistente Bakterien Was bedeuten sie für uns? Hygiene im Langzeitpflegebereich, PZ Gerenholz, 19.5.2016 Gerhard Eich Infektiologie/Spitalhygiene Stadtspitäler Triemli & Waid Patient, geb. 1949 Persönliche
Antibiotika-Empfindlichkeit von HWI-Erregern
 Bad Honnef-Symposium 212, 16./17. April 212 Venerologische und urogenitale Infektionen Antibiotika-Empfindlichkeit von HWI-Erregern Michael Kresken Paul-Ehrlich-Gesellschaft für Chemotherapie e.v., Campus
Bad Honnef-Symposium 212, 16./17. April 212 Venerologische und urogenitale Infektionen Antibiotika-Empfindlichkeit von HWI-Erregern Michael Kresken Paul-Ehrlich-Gesellschaft für Chemotherapie e.v., Campus
Antibiotikatherapie - Grundlagen
 KLINIK UND POLIKLINIK FÜR INNERE MEDIZIN I Antibiotikatherapie - Grundlagen B. Salzberger Hemmung der Zellwandsynthese: Penicilline, Cephalosporine, Glykopeptid-AB, Fosfomycin Proteinsynthese (Translation)
KLINIK UND POLIKLINIK FÜR INNERE MEDIZIN I Antibiotikatherapie - Grundlagen B. Salzberger Hemmung der Zellwandsynthese: Penicilline, Cephalosporine, Glykopeptid-AB, Fosfomycin Proteinsynthese (Translation)
Definition der Multiresistenz
 Neue Empfehlung der Kommission für Krankenhaushygiene und Infektionsprävention (KRINKO) beim Robert Koch-Institut (RKI): Hygienemaßnahmen bei Infektionen oder Besiedlung mit multiresistenten gramnegativen
Neue Empfehlung der Kommission für Krankenhaushygiene und Infektionsprävention (KRINKO) beim Robert Koch-Institut (RKI): Hygienemaßnahmen bei Infektionen oder Besiedlung mit multiresistenten gramnegativen
Multiresistente gramnegative Bakterien (MRGN, früher ESBL-Bildner)
 Institut für Medizinische Mikrobiologie und Hygiene Seite 1 von 8 Multiresistente gramnegative Bakterien (MRGN, früher ESBL-Bildner) Erreger: gramnegative Stäbchenbakterien, mit Resistenzen gegenüber Standard-Antibiotika:
Institut für Medizinische Mikrobiologie und Hygiene Seite 1 von 8 Multiresistente gramnegative Bakterien (MRGN, früher ESBL-Bildner) Erreger: gramnegative Stäbchenbakterien, mit Resistenzen gegenüber Standard-Antibiotika:
Hygienemaßnahmen bei MRGN: Gibt es da was Neues? Prof. Dr. med. M. Trautmann Institut für Krankenhaushygiene, Klinikum Stuttgart
 Hygienemaßnahmen bei MRGN: Gibt es da was Neues? Prof. Dr. med. M. Trautmann Institut für Krankenhaushygiene, Klinikum Stuttgart MRGN-Erreger versus ESBL-Bildner Leider immer noch eine Begriffsverwirrung!
Hygienemaßnahmen bei MRGN: Gibt es da was Neues? Prof. Dr. med. M. Trautmann Institut für Krankenhaushygiene, Klinikum Stuttgart MRGN-Erreger versus ESBL-Bildner Leider immer noch eine Begriffsverwirrung!
Import von ESBL und Carbapenemase- bildendenden Enterobacteriaceae nach Deutschland durch Reisende
 Import von ESBL und Carbapenemase- bildendenden Enterobacteriaceae nach Deutschland durch Reisende Laurentia Straube und Christoph Lübbert Fachbereich Infektions- und Tropenmedizin Klinik für Gastroenterologie
Import von ESBL und Carbapenemase- bildendenden Enterobacteriaceae nach Deutschland durch Reisende Laurentia Straube und Christoph Lübbert Fachbereich Infektions- und Tropenmedizin Klinik für Gastroenterologie
Multiresistente Erreger
 Multiresistente Erreger MRSA, VRE, ESBL Sept. 2009 1 zeitliches Auftreten der Resistenzen 1960 HA-MRSA Methicillinresistenter Staphylococcus aureus 1993 CA-MRSA 1986 VRE Vancomycinresistanter Enterococcus
Multiresistente Erreger MRSA, VRE, ESBL Sept. 2009 1 zeitliches Auftreten der Resistenzen 1960 HA-MRSA Methicillinresistenter Staphylococcus aureus 1993 CA-MRSA 1986 VRE Vancomycinresistanter Enterococcus
M. Mielke, N.-O. Hübner, RKI
 Nosokomiale und schwierig zu therapierende Infektionen IfSG und aktuelle Empfehlungen der KRINKO Aufmerksamkeit - Wissen - Verantwortung MRGN Was ist das? Was ist zu tun? M. Mielke, N.-O. Hübner, RKI Novellierung
Nosokomiale und schwierig zu therapierende Infektionen IfSG und aktuelle Empfehlungen der KRINKO Aufmerksamkeit - Wissen - Verantwortung MRGN Was ist das? Was ist zu tun? M. Mielke, N.-O. Hübner, RKI Novellierung
29.04.2014. Rationaler Antibiotikaeinsatz. in Zeiten zunehmender Antibiotikaresistenz. Auswahlkriterien für die Zusammenarbeit mit dem Mikrobiologen
 Auswahlkriterien für die Zusammenarbeit mit dem Mikrobiologen ationaler Antibiotikaeinsatz in der Praxis in Zeiten zunehmender Antibiotikaresistenz Kurze Transportzeiten Heißer Draht Keine überflüssige
Auswahlkriterien für die Zusammenarbeit mit dem Mikrobiologen ationaler Antibiotikaeinsatz in der Praxis in Zeiten zunehmender Antibiotikaresistenz Kurze Transportzeiten Heißer Draht Keine überflüssige
Pseudomonas aeruginosa Acinetobacter Baumannii. Gramnegative MRE. Bedeutung und Hygienemaßnahmen
 Pseudomonas aeruginosa Acinetobacter Baumannii Gramnegative MRE E. Coli Stenotrophomonas maltophilia Bedeutung und Hygienemaßnahmen Dr. Gabriele Sinn Gesundheitsamt Charlottenburg-Wilmersdorf von Berlin
Pseudomonas aeruginosa Acinetobacter Baumannii Gramnegative MRE E. Coli Stenotrophomonas maltophilia Bedeutung und Hygienemaßnahmen Dr. Gabriele Sinn Gesundheitsamt Charlottenburg-Wilmersdorf von Berlin
Empfehlungen der KRINKO zum Umgang mit ESBL MRGN. Prof. Dr. C. Wendt
 Empfehlungen der KRINKO zum Umgang mit ESBL MRGN Prof. Dr. C. Wendt Alle Krankenhäuser MRSA 3/4 MRGN E. coli und Klebs. Trend MRSA Trend 4/4 MRGN E. coli Klbes. 3500 3000 2500 Patienten 2000 1500 1000
Empfehlungen der KRINKO zum Umgang mit ESBL MRGN Prof. Dr. C. Wendt Alle Krankenhäuser MRSA 3/4 MRGN E. coli und Klebs. Trend MRSA Trend 4/4 MRGN E. coli Klbes. 3500 3000 2500 Patienten 2000 1500 1000
Nosokomiale Infektionen: Die Fakten
 Geffers U N I V E R S I T Ä T S M E D I Z I N B E R L I N Nosokomiale Infektionen: Die Fakten Christine Geffers Institut für Hygiene und Umweltmedizin, Charité-Universitätsmedizin Berlin Nationales Referenzzentrum
Geffers U N I V E R S I T Ä T S M E D I Z I N B E R L I N Nosokomiale Infektionen: Die Fakten Christine Geffers Institut für Hygiene und Umweltmedizin, Charité-Universitätsmedizin Berlin Nationales Referenzzentrum
ESBL-, AmpC-und Carbapenemase-bildende Keime beim Menschen
 ESBL-, AmpC-und Carbapenemase-bildende Keime beim Menschen FG13 Nosokomiale Infektionserreger und Antibiotikaresistenzen Robert Koch-Institut, Bereich Wernigerode BfR Symposium Antibiotikaresistenzen in
ESBL-, AmpC-und Carbapenemase-bildende Keime beim Menschen FG13 Nosokomiale Infektionserreger und Antibiotikaresistenzen Robert Koch-Institut, Bereich Wernigerode BfR Symposium Antibiotikaresistenzen in
MRGN Gramnegative Erreger rüsten auf
 MRGN Gramnegative Erreger rüsten auf Dr. Christina Dörbecker 10.02.2015 1 Generalanzeiger Bonn 26. Januar 2015 74 jähriger Deutscher nach Türkeiurlaub wird am 11.12.2014 in der Uniklinik Kiel aufgenommen,
MRGN Gramnegative Erreger rüsten auf Dr. Christina Dörbecker 10.02.2015 1 Generalanzeiger Bonn 26. Januar 2015 74 jähriger Deutscher nach Türkeiurlaub wird am 11.12.2014 in der Uniklinik Kiel aufgenommen,
PHARMAKOKINETIK UND DOSIERUNG VON RESERVEANTIBIOTIKA BEI KINDERN
 CAMPUS INNENSTADT KINDERKLINIK UND KINDERPOLIKLINIK IM DR. V. HAUNERSCHEN KINDERSPITAL PHARMAKOKINETIK UND DOSIERUNG VON RESERVEANTIBIOTIKA BEI KINDERN Johannes Hübner Abteilung Pädiatrische Infektiologie
CAMPUS INNENSTADT KINDERKLINIK UND KINDERPOLIKLINIK IM DR. V. HAUNERSCHEN KINDERSPITAL PHARMAKOKINETIK UND DOSIERUNG VON RESERVEANTIBIOTIKA BEI KINDERN Johannes Hübner Abteilung Pädiatrische Infektiologie
München. Antibiotikaresistenzen. Zentrales Institut des Sanitätsdienstes der Bundeswehr. OFA Dr. Irene Wolff, Lab Abt I Medizin
 Zentrales Institut des Sanitätsdienstes der Bundeswehr München Antibiotikaresistenzen OFA Dr. Irene Wolff, Lab Abt I Medizin Aktuell und brisant.. Welt Online 8.6.2015 Quelle: Deutsches Ärzteblatt wir
Zentrales Institut des Sanitätsdienstes der Bundeswehr München Antibiotikaresistenzen OFA Dr. Irene Wolff, Lab Abt I Medizin Aktuell und brisant.. Welt Online 8.6.2015 Quelle: Deutsches Ärzteblatt wir
UNIVERSALINSTRUMENT ANTIBIOTIKUM?
 CAMPUS GROSSHADERN CAMPUS INNENSTADT UNIVERSALINSTRUMENT ANTIBIOTIKUM? Dr. Béatrice Grabein Stabsstelle Klinische Mikrobiologie und Krankenhaushygiene 02.04.2014 B. Grabein DIE INSTRUMENTE Daptomycin Aminoglykoside
CAMPUS GROSSHADERN CAMPUS INNENSTADT UNIVERSALINSTRUMENT ANTIBIOTIKUM? Dr. Béatrice Grabein Stabsstelle Klinische Mikrobiologie und Krankenhaushygiene 02.04.2014 B. Grabein DIE INSTRUMENTE Daptomycin Aminoglykoside
Multiresistente Nonfermenter
 Multiresistente Nonfermenter 8. Hygiene Forum Bonn Neue Entwicklungen und Herausforderungen in der Hygiene 08. September 2011 Dr. Stephan Wydra Institut für Hygiene und Öffentliche Gesundheit, Universitätsklinikum
Multiresistente Nonfermenter 8. Hygiene Forum Bonn Neue Entwicklungen und Herausforderungen in der Hygiene 08. September 2011 Dr. Stephan Wydra Institut für Hygiene und Öffentliche Gesundheit, Universitätsklinikum
Es ist fünf vor zwölf gramnegative multiresistente Erreger im Blickpunkt. Prof. Dr. C. Wendt
 Es ist fünf vor zwölf gramnegative multiresistente Erreger im Blickpunkt Prof. Dr. C. Wendt Definition der Multiresistenz Resistenz gegen mehrere Antibiotikaklassen MDRO-Guideline 2006 Resistenz gegenüber
Es ist fünf vor zwölf gramnegative multiresistente Erreger im Blickpunkt Prof. Dr. C. Wendt Definition der Multiresistenz Resistenz gegen mehrere Antibiotikaklassen MDRO-Guideline 2006 Resistenz gegenüber
Resistente Erreger. Andreas F. Widmer, MD,MS, FIDSA,FSHEA
 Resistente Erreger Andreas F. Widmer, MD,MS, FIDSA,FSHEA Stv. Chefarzt Klinik für Infektiologie & Spitalhygiene und Leiter Spitalhygiene Präsident Swissnoso Core member Patient safety WHO Genf http://www.who.int/patientsafety/en/
Resistente Erreger Andreas F. Widmer, MD,MS, FIDSA,FSHEA Stv. Chefarzt Klinik für Infektiologie & Spitalhygiene und Leiter Spitalhygiene Präsident Swissnoso Core member Patient safety WHO Genf http://www.who.int/patientsafety/en/
Antibiotika. Definition. Bedeutung. Substanzen, die den Infektionserreger, aber nicht den Makroorganismus schädigen. (Paul Ehrlich: Magische Kugel )
Antibiotika Definition Substanzen, die den Infektionserreger, aber nicht den Makroorganismus schädigen. (Paul Ehrlich: Magische Kugel ) Bedeutung Bis zu 50% des Arzneietats eines Krankenhauses Seite 1/64
Antibiotika Definition Substanzen, die den Infektionserreger, aber nicht den Makroorganismus schädigen. (Paul Ehrlich: Magische Kugel ) Bedeutung Bis zu 50% des Arzneietats eines Krankenhauses Seite 1/64
Krankenhaus-Hygiene Aktuell
 Krankenhaus-Hygiene Aktuell Juni 2015 Gundi Heuschen Weltweite Situation Globaler Reiseverkehr: Schnelle Verbreitung weltweit innerhalb weniger Stunden Steigende Infektionsraten Zunehmende Antibiotikaresistenzen
Krankenhaus-Hygiene Aktuell Juni 2015 Gundi Heuschen Weltweite Situation Globaler Reiseverkehr: Schnelle Verbreitung weltweit innerhalb weniger Stunden Steigende Infektionsraten Zunehmende Antibiotikaresistenzen
MRSA Schluss mit Mythen
 Stefan Borgmann MRSA Schluss mit Mythen Klinikum Ingolstadt Neue MRSA Antibiotika Name Wirkort Indikation Keine Indikation Nebenwirkungen Kontraindikation Dosierung Kosten / Tag Ceftarolin (Zinforo) (Teflaro)
Stefan Borgmann MRSA Schluss mit Mythen Klinikum Ingolstadt Neue MRSA Antibiotika Name Wirkort Indikation Keine Indikation Nebenwirkungen Kontraindikation Dosierung Kosten / Tag Ceftarolin (Zinforo) (Teflaro)
Erregerhäufigkeit bei akuter bakterieller Meningitis
 Erregerhäufigkeit bei akuter bakterieller Meningitis 70 60 % 50 40 30 20 10 Listeria B-Streptok. N. meningitidis S. pneumoniae H. influenzae 0 60 J. Schuchat et al
Erregerhäufigkeit bei akuter bakterieller Meningitis 70 60 % 50 40 30 20 10 Listeria B-Streptok. N. meningitidis S. pneumoniae H. influenzae 0 60 J. Schuchat et al
Hygienemaßnahmen bei 3 und 4 MRGN Erreger in der stationären und ambulanten Versorgung
 Hygienemaßnahmen bei 3 und 4 MRGN Erreger in der stationären und ambulanten Versorgung Vortrag von Nicole Demuth-Werner HFK in der Kath. Krankenhaus Hagen gem. GmbH 2 3 Was Sie erwartet: Erregervorstellung
Hygienemaßnahmen bei 3 und 4 MRGN Erreger in der stationären und ambulanten Versorgung Vortrag von Nicole Demuth-Werner HFK in der Kath. Krankenhaus Hagen gem. GmbH 2 3 Was Sie erwartet: Erregervorstellung
Carbapenemresistenz bei Gram-negativen Bakterien Hype oder reale Bedrohung?
 Fortbildung für den Öffentlichen Gesundheitsdienst, Berlin 23.-25. März 2011 Carbapenemresistenz bei Gram-negativen Bakterien Hype oder reale Bedrohung? E. coli P. aeruginosa K. pneumoniae A. baumannii
Fortbildung für den Öffentlichen Gesundheitsdienst, Berlin 23.-25. März 2011 Carbapenemresistenz bei Gram-negativen Bakterien Hype oder reale Bedrohung? E. coli P. aeruginosa K. pneumoniae A. baumannii
Fallvignette. Antibiotika bei Zystitis: Stellenwert der ESBL Bakterien? Welche Zusatzinformationen benötigen Sie um einem HWI zu diagnostizieren?
 18. ymposium Infektionskrankheiten in der Praxis Fallvignette Antibiotika bei Zystitis: tellenwert der EBL Bakterien? [email protected] Antimikrobielle Therapie bei Harnswegsinfektionen (HWI) Plazebo
18. ymposium Infektionskrankheiten in der Praxis Fallvignette Antibiotika bei Zystitis: tellenwert der EBL Bakterien? [email protected] Antimikrobielle Therapie bei Harnswegsinfektionen (HWI) Plazebo
Infektionen bei Nierentransplantierten Eine Herausforderung
 Infektionen bei Nierentransplantierten Eine Herausforderung Vicky Samuel Klinik für Allgemein-, Viszeral-, und Transplantationschirurgie Transplantationszentrum Modifiedfrom Rubin et al, Clinicalapproachto
Infektionen bei Nierentransplantierten Eine Herausforderung Vicky Samuel Klinik für Allgemein-, Viszeral-, und Transplantationschirurgie Transplantationszentrum Modifiedfrom Rubin et al, Clinicalapproachto
Diagnostik und molekulare Epidemiologie multiresistenter Gram-negativer Bakterien
 Fachtagung Krankenhaushygiene, Halle/Saale, 13. April 2011 Diagnostik und molekulare Epidemiologie multiresistenter Gram-negativer Bakterien E. coli P. aeruginosa K. pneumoniae A. baumannii Dr. rer. nat.
Fachtagung Krankenhaushygiene, Halle/Saale, 13. April 2011 Diagnostik und molekulare Epidemiologie multiresistenter Gram-negativer Bakterien E. coli P. aeruginosa K. pneumoniae A. baumannii Dr. rer. nat.
Was sind. -wiewerden sie verbreitet? - 17.4.2013. S. Kolbe-Busch
 Was sind Multiresistente Erreger -wiewerden sie verbreitet? KOMET-MREMRE - 17.4.2013 S. Kolbe-Busch Institut für Medizinische Mikrobiologie und Krankenhaushygiene Mit wem haben wir es zu tun? MRSA VRE
Was sind Multiresistente Erreger -wiewerden sie verbreitet? KOMET-MREMRE - 17.4.2013 S. Kolbe-Busch Institut für Medizinische Mikrobiologie und Krankenhaushygiene Mit wem haben wir es zu tun? MRSA VRE
Fachinformation synlab.vet. Multiresistente Erreger. MRS(A), ESBL & Co
 Fachinformation synlab.vet Multiresistente Erreger MRS(A), ESBL & Co Multiresistente Erreger, MRS(A), ESBL & Co Einleitung Ein gravierendes und hochaktuelles Problem ist die Entstehung und Ausbreitung
Fachinformation synlab.vet Multiresistente Erreger MRS(A), ESBL & Co Multiresistente Erreger, MRS(A), ESBL & Co Einleitung Ein gravierendes und hochaktuelles Problem ist die Entstehung und Ausbreitung
Harnwegsinfektionen von der Hausarztpraxis bis zur Intensivstation. Professor Christian Ruef Institut für Infektiologie und Spitalhygiene
 Harnwegsinfektionen von der Hausarztpraxis bis zur Intensivstation Professor Christian Ruef Institut für Infektiologie und Spitalhygiene 1 Themen Fallbeispiel Epidemiologie der Antibiotikaresistenz - International
Harnwegsinfektionen von der Hausarztpraxis bis zur Intensivstation Professor Christian Ruef Institut für Infektiologie und Spitalhygiene 1 Themen Fallbeispiel Epidemiologie der Antibiotikaresistenz - International
Hygienemaßnahmen bei Infektionen oder Besiedlung mit multiresistenten gramnegativen bakteriellen Erregern
 Hygienemaßnahmen bei Infektionen oder Besiedlung mit multiresistenten gramnegativen bakteriellen Erregern Eine Musterpräsentation des Robert Koch-Institutes Erstellt von: PD Dr. Nils-Olaf Hübner in Abstimmung
Hygienemaßnahmen bei Infektionen oder Besiedlung mit multiresistenten gramnegativen bakteriellen Erregern Eine Musterpräsentation des Robert Koch-Institutes Erstellt von: PD Dr. Nils-Olaf Hübner in Abstimmung
Bundesgesundheitsbl 2012 55:1311 1354 DOI 10.1007/s00103-012-1549-5 Springer-Verlag 2012 Hygienemaßnahmen bei
 Bundesgesundheitsbl 2012 55:1311 1354 DOI 10.1007/s00103-012-1549-5 Springer-Verlag 2012 Hygienemaßnahmen bei Infektionen oder Besiedlung mit multiresistenten gramnegativen Stäbchen Empfehlung der Kommission
Bundesgesundheitsbl 2012 55:1311 1354 DOI 10.1007/s00103-012-1549-5 Springer-Verlag 2012 Hygienemaßnahmen bei Infektionen oder Besiedlung mit multiresistenten gramnegativen Stäbchen Empfehlung der Kommission
SARI http://www.antibiotika-sari.de 1
 Daten zum Verbrauch der teilnehmenden Intensivstationen im Zeitverlauf Antibiotikaverbrauch: n=116 Antimykotikaverbrauch: n=94 Institut für Umweltmedizin und Krankenhaushygiene Breisacher Str. 115 b 7916
Daten zum Verbrauch der teilnehmenden Intensivstationen im Zeitverlauf Antibiotikaverbrauch: n=116 Antimykotikaverbrauch: n=94 Institut für Umweltmedizin und Krankenhaushygiene Breisacher Str. 115 b 7916
KPC & Screening Von schrecklichen Resistenzen, wie sie uns plagen, und wie wir uns wehren können, auch wenn wir nicht viele Mittel haben
 KPC & Screening Von schrecklichen Resistenzen, wie sie uns plagen, und wie wir uns wehren können, auch wenn wir nicht viele Mittel haben HiO Nottwil, 7. März 2016 PD Dr. med. Jonas Marschall Leitung Spitalhygiene,
KPC & Screening Von schrecklichen Resistenzen, wie sie uns plagen, und wie wir uns wehren können, auch wenn wir nicht viele Mittel haben HiO Nottwil, 7. März 2016 PD Dr. med. Jonas Marschall Leitung Spitalhygiene,
Antibiotikastrategien bei multiresistenten Erregern
 Antibiotikastrategien bei multiresistenten Erregern Dr. Margret Seewald FÄ f. Mikrobiologie u. Infektionsepidemiologie Umweltmedizin / Ärztliches Qualitätsmanagement Praxis Center Nord Berlin Drontheimer
Antibiotikastrategien bei multiresistenten Erregern Dr. Margret Seewald FÄ f. Mikrobiologie u. Infektionsepidemiologie Umweltmedizin / Ärztliches Qualitätsmanagement Praxis Center Nord Berlin Drontheimer
Beta-Lactamasen und Beta-Lactamase- Inhibitoren
 Übersicht Beta-Lactamasen und Beta-Lactamase- Inhibitoren Ursula Theuretzbacher, Wien Die Bildung von Beta-Lactamasen ist der häufigste Resistenzmechanismus gegenüber Beta-Lactam-Antibiotika. Die Enzyme
Übersicht Beta-Lactamasen und Beta-Lactamase- Inhibitoren Ursula Theuretzbacher, Wien Die Bildung von Beta-Lactamasen ist der häufigste Resistenzmechanismus gegenüber Beta-Lactam-Antibiotika. Die Enzyme
Neue Meldepflichten: IfSG-Meldepflicht- Anpassungsverordnung (IfSGMeldAnpV) Netzwerktag im mre-netzwerk HSK am
 Neue Meldepflichten: IfSG-Meldepflicht- Anpassungsverordnung (IfSGMeldAnpV) Netzwerktag im mre-netzwerk HSK am Allgemeines Am 18.März 2016 wurde vom Bundesgesundheitsministerium eine neue Verordnung zur
Neue Meldepflichten: IfSG-Meldepflicht- Anpassungsverordnung (IfSGMeldAnpV) Netzwerktag im mre-netzwerk HSK am Allgemeines Am 18.März 2016 wurde vom Bundesgesundheitsministerium eine neue Verordnung zur
NEWSLETTER. Inhalt. Multiresistente Erreger und deren Nachweis 10/2010
 NEWSLETTER 10/2010 Inhalt CHROMagar TM MRSA CHROMagar TM ESBL CHROMagar TM CTX-M CHROMagar TM KPC CHROMagar TM VRE CHROMagar TM Acinetobacter Multiresistente Erreger und deren Nachweis Vor wenigen Tagen
NEWSLETTER 10/2010 Inhalt CHROMagar TM MRSA CHROMagar TM ESBL CHROMagar TM CTX-M CHROMagar TM KPC CHROMagar TM VRE CHROMagar TM Acinetobacter Multiresistente Erreger und deren Nachweis Vor wenigen Tagen
Situation im Antibiotikaverbrauch und Erregerresistenz in der Humanmedizin
 Interdisziplinäres Symposium Antibiotikaresistenz Vom Wissen zum Handeln 19. / 20. September 2012 - Erlangen Situation im Antibiotikaverbrauch und Erregerresistenz in der Humanmedizin Michael Kresken Paul-Ehrlich-Gesellschaft
Interdisziplinäres Symposium Antibiotikaresistenz Vom Wissen zum Handeln 19. / 20. September 2012 - Erlangen Situation im Antibiotikaverbrauch und Erregerresistenz in der Humanmedizin Michael Kresken Paul-Ehrlich-Gesellschaft
MULTIRESISTENTE GRAMPOSITIVE UND GRAMNEGATIVE ERREGER. Dr. O. Janata FA für Infektionskrankheiten Hygieneteam des DSP Wien
 MULTIRESISTENTE GRAMPOSITIVE UND GRAMNEGATIVE ERREGER Dr. O. Janata FA für Infektionskrankheiten Hygieneteam des DSP Wien WARUM SIND ERREGER GEGEN ANTIBIOTIKA RESISTENT? Meropenem as predictive risk
MULTIRESISTENTE GRAMPOSITIVE UND GRAMNEGATIVE ERREGER Dr. O. Janata FA für Infektionskrankheiten Hygieneteam des DSP Wien WARUM SIND ERREGER GEGEN ANTIBIOTIKA RESISTENT? Meropenem as predictive risk
Antibiotikatherapien heute: ist eine Rückfall in die präantibiotische Ära noch zu verhindern?
 Antibiotikatherapien heute: ist eine Rückfall in die präantibiotische Ära noch zu verhindern? Freitag, 22, April 2016 Irene Vogel Kahmann Spitalapothekerin FPH Fähigkeitsausweis klinische Pharmazie FPH
Antibiotikatherapien heute: ist eine Rückfall in die präantibiotische Ära noch zu verhindern? Freitag, 22, April 2016 Irene Vogel Kahmann Spitalapothekerin FPH Fähigkeitsausweis klinische Pharmazie FPH
Der Harnwegsinfekt - Therapie -
 Der Harnwegsinfekt - Therapie - Harnwegsinfektion Verhältnis Frauen/Männer Mindestens 50 % der Frauen entwickeln wenigstens einmal einen Harnwegsinfekt Seit 8 Monaten immer wieder Harnwegsinfekte 29 jährige
Der Harnwegsinfekt - Therapie - Harnwegsinfektion Verhältnis Frauen/Männer Mindestens 50 % der Frauen entwickeln wenigstens einmal einen Harnwegsinfekt Seit 8 Monaten immer wieder Harnwegsinfekte 29 jährige
Bessere Diagnostik von Lungeninfekten durch Multiplex-PCR?
 Bessere Diagnostik von Lungeninfekten durch Multiplex-PCR? Dr. med. Reno Frei Klinische Mikrobiologie Universitätsspital Basel CH-4031 Basel [email protected] Pneumonie Ambulant erworbene P. (CAP): 3-8/1000
Bessere Diagnostik von Lungeninfekten durch Multiplex-PCR? Dr. med. Reno Frei Klinische Mikrobiologie Universitätsspital Basel CH-4031 Basel [email protected] Pneumonie Ambulant erworbene P. (CAP): 3-8/1000
ANTIBIOGRAMME - Interpretationshilfe -
 Institut für Medizinische Mikrobiologie und Hygiene Abteilung: Klinische Diagnostik ANTIBIOGRAMME - Interpretationshilfe - Institut für Medizinische Mikrobiologie und Hygiene Abteilung: Klinische Diagnostik
Institut für Medizinische Mikrobiologie und Hygiene Abteilung: Klinische Diagnostik ANTIBIOGRAMME - Interpretationshilfe - Institut für Medizinische Mikrobiologie und Hygiene Abteilung: Klinische Diagnostik
Infektionen oder Besiedlung mit MRGN
 Infektionen oder Besiedlung mit MRGN Umsetzung der KRINKO Empfehlung Vortrag von Nicole Demuth-Werner und Jutta Weiland 31.10.2014 Nicole Demuth-Werner, Jutta Weiland 2 Was Sie erwartet: Erregervorstellung
Infektionen oder Besiedlung mit MRGN Umsetzung der KRINKO Empfehlung Vortrag von Nicole Demuth-Werner und Jutta Weiland 31.10.2014 Nicole Demuth-Werner, Jutta Weiland 2 Was Sie erwartet: Erregervorstellung
Die kleine Keimkunde: Mehr zu dem Thema auf www.krankenhaushasser.de
 Die kleine Keimkunde: Mehr zu dem Thema auf www.krankenhaushasser.de In den Tabellen sind für einige Keime die im Jahr 2012 (Stand 15.05.13) mithilfe von ARS vom Robert-Koch-Institut ermittelten Resistenzen
Die kleine Keimkunde: Mehr zu dem Thema auf www.krankenhaushasser.de In den Tabellen sind für einige Keime die im Jahr 2012 (Stand 15.05.13) mithilfe von ARS vom Robert-Koch-Institut ermittelten Resistenzen
Vorkommen und Charakterisierung von Extended-Spectrum- Beta-Laktamase (ESBL)-produzierenden Escherichia coli bei Lebensmittel liefernden Tieren
 Aus dem Institut für Mikrobiologie und Tierseuchen des Fachbereichs Veterinärmedizin der Freien Universität Berlin und dem Bundesamt für Verbraucherschutz und Lebensmittelsicherheit Vorkommen und Charakterisierung
Aus dem Institut für Mikrobiologie und Tierseuchen des Fachbereichs Veterinärmedizin der Freien Universität Berlin und dem Bundesamt für Verbraucherschutz und Lebensmittelsicherheit Vorkommen und Charakterisierung
Problemkeime und rationale Antibiotikatherapie in der Nierentransplantation
 Problemkeime und rationale Antibiotikatherapie in der Nierentransplantation Priv. Doz. Dr. Reinhard Hoffmann Institut für Labormedizin und Mikrobiologie Infektionen nach Transplantation: Zeitverlauf Fishman,
Problemkeime und rationale Antibiotikatherapie in der Nierentransplantation Priv. Doz. Dr. Reinhard Hoffmann Institut für Labormedizin und Mikrobiologie Infektionen nach Transplantation: Zeitverlauf Fishman,
8 Antibiotika, Antimykotika: Spektrum Dosierung Nebenwirkungen
 8 Antibiotika, Antimykotika: Spektrum Dosierung Nebenwirkungen Amoxicillin Amoxypen j Grampositive (nicht S. aureus) und gramnegative Keime (H. influenzae ca. 10 % Resistenz) * Erwachsene, Kinder 412 Jahre
8 Antibiotika, Antimykotika: Spektrum Dosierung Nebenwirkungen Amoxicillin Amoxypen j Grampositive (nicht S. aureus) und gramnegative Keime (H. influenzae ca. 10 % Resistenz) * Erwachsene, Kinder 412 Jahre
hmm-newsletter 8 (vom 1.09.2015)
 hmm-newsletter 8 (vom 1.09.2015) KRANKENHAUSHYGIENE PROBLEMKEIME UND BARRIEREMASSNAHMEN Michael Berktold, Sektion HMM, Hygieneteam Landeskrankenhaus Innsbruck/ Universitätskliniken [email protected]
hmm-newsletter 8 (vom 1.09.2015) KRANKENHAUSHYGIENE PROBLEMKEIME UND BARRIEREMASSNAHMEN Michael Berktold, Sektion HMM, Hygieneteam Landeskrankenhaus Innsbruck/ Universitätskliniken [email protected]
Update. Multiresistente Erreger. Dr. med. Bettina Tiemer Laborärztliche Gemeinschaftspraxis Lübeck
 Multiresistente Erreger Update Dr. med. Bettina Tiemer Laborärztliche Gemeinschaftspraxis Lübeck Nationales Referenzzentrum für Surveillance von nosokomialen Infektionen Jährlich infizieren sich bis zu
Multiresistente Erreger Update Dr. med. Bettina Tiemer Laborärztliche Gemeinschaftspraxis Lübeck Nationales Referenzzentrum für Surveillance von nosokomialen Infektionen Jährlich infizieren sich bis zu
Klaus Otto Fachkrankenpfleger für Hygiene
 Klaus Otto Fachkrankenpfleger für Hygiene Keimbesiedelung in Wunden Endogen werden Prozesse bezeichnet, die im Körper selbst und nicht durch äußere Einflüsse entstanden sind z.b. endogene Infektionen.
Klaus Otto Fachkrankenpfleger für Hygiene Keimbesiedelung in Wunden Endogen werden Prozesse bezeichnet, die im Körper selbst und nicht durch äußere Einflüsse entstanden sind z.b. endogene Infektionen.
von Elke Halle Institut für Mikrobiologie und Hygiene, Charité, Berlin
 Brauchen wir ein Referenzlabor für die Resistenztestung? Besser Antiinfektiva-Resistenz von Elke Halle Institut für Mikrobiologie und Hygiene, Charité, Berlin Aufgaben eines Referenzlabors für Antiinfektiva-Resistenz
Brauchen wir ein Referenzlabor für die Resistenztestung? Besser Antiinfektiva-Resistenz von Elke Halle Institut für Mikrobiologie und Hygiene, Charité, Berlin Aufgaben eines Referenzlabors für Antiinfektiva-Resistenz
Kommentar zum Ringversuch B9 Mikrobiologie
 Verein für medizinische Qualitätskontrolle Association pour le contrôle de Qualité medical Associazione per il controllo di qualità medico Kommentar zum Ringversuch B9 Mikrobiologie 2014-1 Probe A: Mittelstrahlurin
Verein für medizinische Qualitätskontrolle Association pour le contrôle de Qualité medical Associazione per il controllo di qualità medico Kommentar zum Ringversuch B9 Mikrobiologie 2014-1 Probe A: Mittelstrahlurin
Albrecht Kern Fachpfleger für Hygiene und Infektionsprävention/HFK
 Albrecht Kern Fachpfleger für Hygiene und Infektionsprävention/HFK Weit, weit weg Die Bundeswehr ist mittlerweile in vielen Teilen der Welt im Einsatz - dort lauern nicht nur menschliche Feinde, sondern
Albrecht Kern Fachpfleger für Hygiene und Infektionsprävention/HFK Weit, weit weg Die Bundeswehr ist mittlerweile in vielen Teilen der Welt im Einsatz - dort lauern nicht nur menschliche Feinde, sondern
MRGN praktische Umsetzung und offene Fragen aus krankenhaushygienischer Sicht
 MRGN praktische Umsetzung und offene Fragen aus krankenhaushygienischer Sicht Dr. med. Georg-Christian Zinn Zentrum für und Infektionsprävention, Bioscientia KPC 7. Juni 2012 12:00 Uniklinikum Leipzig
MRGN praktische Umsetzung und offene Fragen aus krankenhaushygienischer Sicht Dr. med. Georg-Christian Zinn Zentrum für und Infektionsprävention, Bioscientia KPC 7. Juni 2012 12:00 Uniklinikum Leipzig
Antibiotika-Resistenz: Aktuelle Herausforderungen in der Veterinärmedizin
 Antibiotika-Resistenz: Was kann ich konkret dagegen unternehmen? Alumni-Vorlesung, 28. April 2016, Bern Antibiotika-Resistenz: Aktuelle Herausforderungen in der Veterinärmedizin Prof. Dr Vincent Perreten
Antibiotika-Resistenz: Was kann ich konkret dagegen unternehmen? Alumni-Vorlesung, 28. April 2016, Bern Antibiotika-Resistenz: Aktuelle Herausforderungen in der Veterinärmedizin Prof. Dr Vincent Perreten
Laboratoriumsmedizin Dortmund Dr.med.Eberhard und Partner Abteilung MIKROBIOLOGIE (www.labmed.de /
 Laboratoriumsmedizin Dortmund Dr.med.Eberhard und Partner Abteilung MIKROBIOLOGIE (www.labmed.de / [email protected]) seit April 2003 Akkreditierung (aktuell DIN EN ISO 15189; DACH) 1 1. Problematik multiresistenter
Laboratoriumsmedizin Dortmund Dr.med.Eberhard und Partner Abteilung MIKROBIOLOGIE (www.labmed.de / [email protected]) seit April 2003 Akkreditierung (aktuell DIN EN ISO 15189; DACH) 1 1. Problematik multiresistenter
Keimspektrum bei HWI
 Keimspektrum bei HWI Enterobakterien 87,1% Escherichia coli 79,8% Proteus mirabilis 5,2% Klebsiella 1,8% Citrobacter 0,3% Grampositive Kokken 11,6% Staphylococcus saprophyticus 3,7% Streptokokken der Gruppe
Keimspektrum bei HWI Enterobakterien 87,1% Escherichia coli 79,8% Proteus mirabilis 5,2% Klebsiella 1,8% Citrobacter 0,3% Grampositive Kokken 11,6% Staphylococcus saprophyticus 3,7% Streptokokken der Gruppe
ESBL. Konsequenzen für die stationäre Pflege
 ESBL Konsequenzen für die stationäre Pflege ESBL-Bildner ESBL = Extended spectrum Betalaktamase ß Laktamase: Ein Enzym, das von den Bakterien gebildet wird und den ß-Laktam Ring der folgenden ß-Laktam
ESBL Konsequenzen für die stationäre Pflege ESBL-Bildner ESBL = Extended spectrum Betalaktamase ß Laktamase: Ein Enzym, das von den Bakterien gebildet wird und den ß-Laktam Ring der folgenden ß-Laktam
